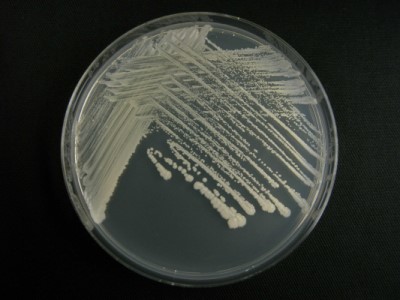
Saccharomyces cerevisiae1
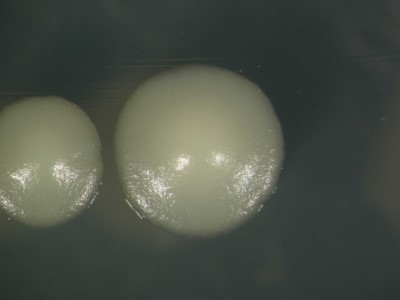
Saccharomyces cerevisiae5

酵母の一種 Saccharomyces cerevisiae
Saccharomyces cerevisiae (サッカロミケス・セレビシエ/サッカロマイセス・セレビシエ) は酵母の一種で、「出芽酵母」や「パン酵母」というと一般的にこの種を示します。ビールや日本酒などのアルコール醸造に欠かせない微生物であると同時に、ヒトと同じ真核生物であることから、モデル生物として古くから様々な研究がなされてきました。「出芽酵母」という名前の通り、1つの母細胞の端から芽が出るように膨らみが生じ、娘細胞ができます。娘細胞が母細胞と同じくらいの大きさまで成長した後、母細胞 (親元) を離れて増殖していきます。
正式な名前 (学名) は、「Saccharomyces cerevisiae (Desm.) Meyen」であり、1838年にMeyenによって命名されました。分類学的には、カビやきのこと同じ「菌類界」に属し、その中でも「子嚢菌門・サッカロミケス亜門・サッカロミケス綱・サッカロミケス目・サッカロミケス科・サッカロミケス属」に分類される種になります。属名の「Saccharomyces」は「ギリシャ語の σάκχαρον (sakcharon) 起源のラテン語の糖 Saccharum とギリシャ語の菌 μύκηs (myces) の複合語で、種小名の「cerevisiae」は「ビールを意味するケルト語起源のラテン語である Cerevisia の属格 Cerevisiae」に由来します。その学名の通り、S. cerevisiaeは糖を代謝しアルコール発酵を行うことが大きな特徴です。自然界のS. cerevisiaeは各種の果実や果汁などの糖質原料、土壌、海や川、葉、樹液などさまざまな場所に生育しています。